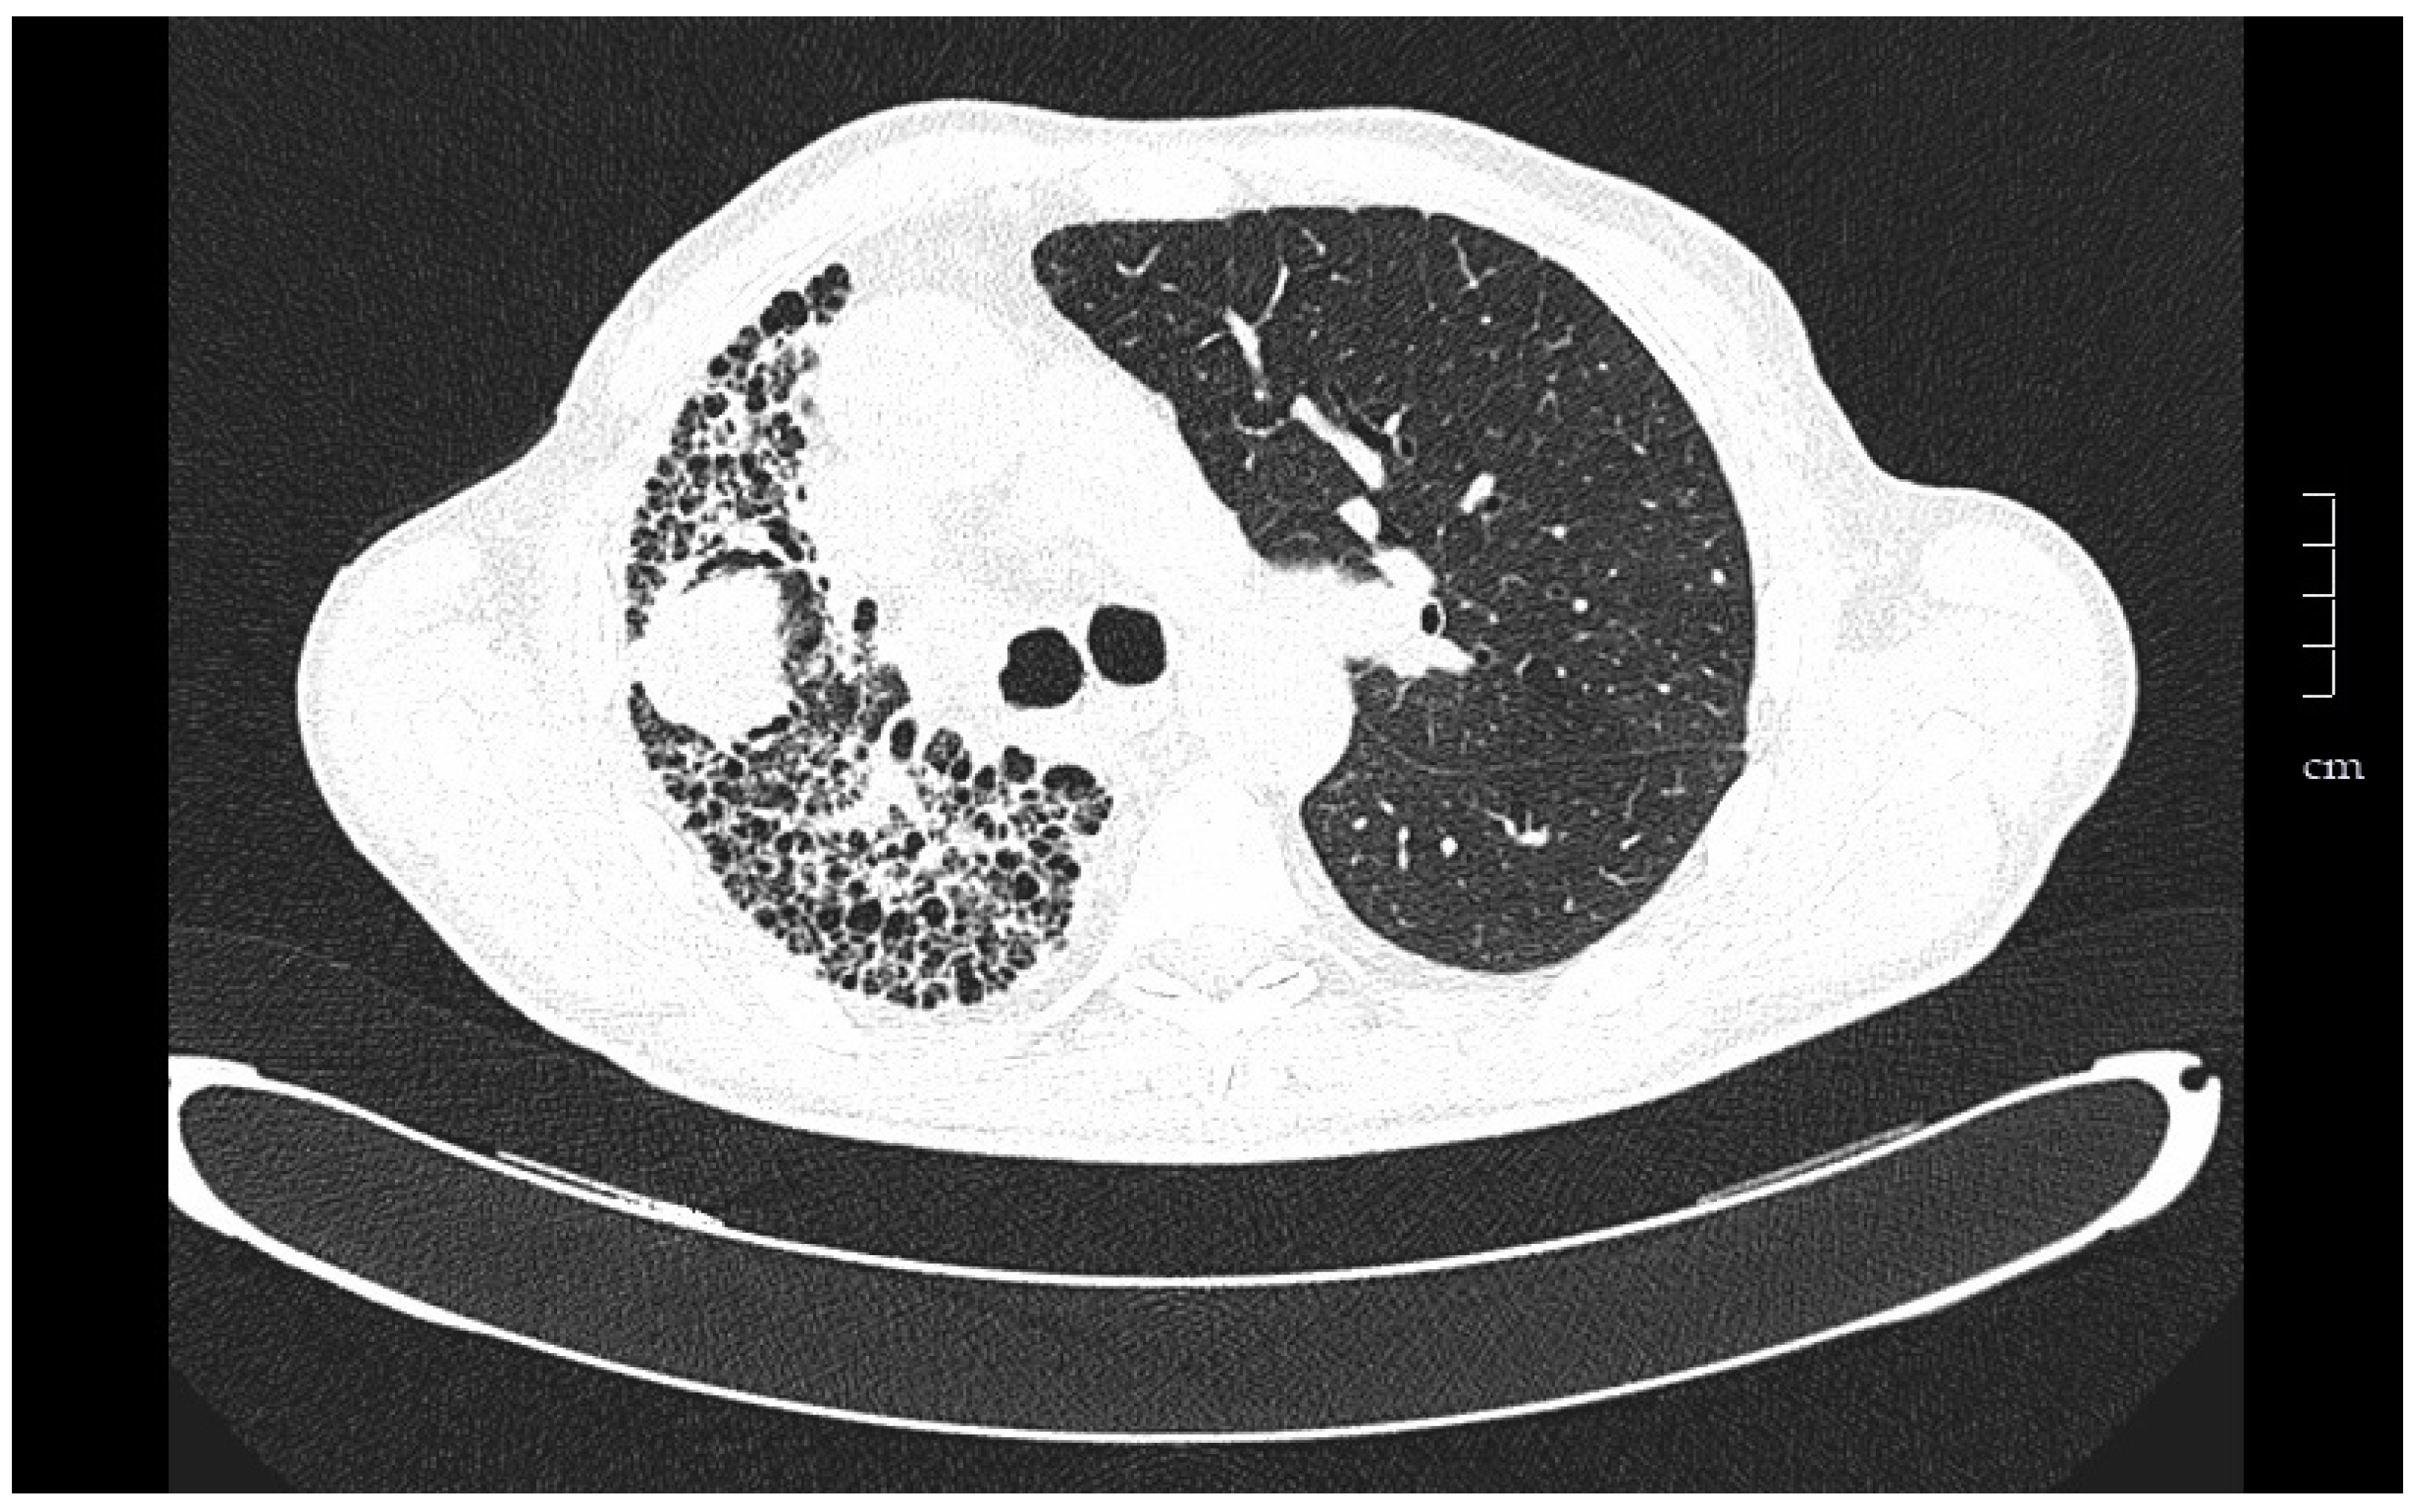
Medsci 06 00068 g001 Medsci 06 00068 g001

Lung Transplantation in Idiopathic Pulmonary Fibrosis
Abstract
1. Introduction
2. Pretransplant Evaluation
2.1. Selection of Patients
2.2. Transplantation Window
2.3. Preoperative Management
3. Type of Transplant
4. Results
4.1. Functional Evolution
4.2. Survival
4.3. Quality of Life
5. Post-Transplant Monitoring
5.1. Follow Up
5.2. Complications
5.2.1. Infections
5.2.2. Chronic Lung Allograft Dysfunction
5.2.3. Neoplasia
6. Conclusions
Author Contributions
Funding
Conflicts of Interest
References
- Hardy, J.D. The first lung transplant in man (1963) and the first heart transplant in man (1964). Transp. Proc. 1999, 31, 25–29. [Google Scholar] [CrossRef]
- Weill, D.; Benden, C.; Corris, P.A.; Dark, J.H.; Davis, R.D.; Keshavjee, S.; Lederer, D.J.; Mulligan, M.J.; Patterson, G.A.; Singer, L.G.; et al. A consensus document for the selection of lung transplant candidates: 2014—An update from the Pulmonary Transplantation Council of the International Society for Heart and Lung Transplantation. J. Heart Lung Transplant. 2015, 34, 1–15. [Google Scholar] [CrossRef] [PubMed]
- Yusen, R.D.; Edwards, L.B.; Kucheryavaya, A.Y.; Benden, C.; Dipchand, A.I.; Dobbels, F.; Goldfarb, S.B.; Levvey, B.J.; Lund, L.H.; Meiser, B.; et al. The registry of the International Society for Heart and Lung Transplantation: Thirty-first adult lung and heart-lung transplant report—2014; focus theme: Retransplantation. J. Heart Lung Transplant. 2014, 33, 1009–1024. [Google Scholar] [CrossRef] [PubMed]
- Merlo, C.; Weiss, E.; Orens, J.; Borja, M.; Diener-West, M.; Conte, J.; Shah, A. Impact of U.S. Lung Allocation Score on survival after lung transplant. J. Heart Lung Transplant. 2009, 28, 769–775. [Google Scholar] [CrossRef] [PubMed]
- Kistler, K.D.; Nalysnyk, L.; Rotella, P.; Esser, D. Lung transplantation in idiopathic pulmonary fibrosis: A systematic review of the literature. BMC Pulm. Med. 2014, 14, 139. [Google Scholar] [CrossRef] [PubMed]
- Spain Transplantation National Data. Available online: www.ont.es (accessed on 5 June 2018).
- Ley, B.; Collard, H.R.; King, T.E., Jr. Clinical course and prediction of survival in idiopathic pulmonary fibrosis. Am. J. Respir. Crit. Care Med. 2011, 183, 431–440. [Google Scholar] [CrossRef] [PubMed]
- Chambers, D.C.; Yusen, R.D.; Cherikh, W.S.; Goldfarb, S.B.; Kucheryavaya, A.Y.; Khusch, K.; Levvey, B.J.; Lund, L.H.; Meiser, B.; Rossano, J.W.; et al. The Registry of the International Society for Heart and Lung Transplantation: Thirty-fourth Adult Lung and Heart-Lung Transplantation Report-2017; Focus Theme: Allograft ischemic time. J. Heart Lung Transplant. 2017, 36, 1047–1059. [Google Scholar] [CrossRef] [PubMed]
- Izbicki, G.; Ben-Dor, I.; Shitrit, D.; Bendayan, D.; Aldrich, T.K.; Aldrich, T.K.; Kornowski, R.; Kramer, M.R. The prevalence of coronary artery disease in end-stage pulmonary disease: Is pulmonary fibrosis a risk factor? Respir. Med. 2009, 103, 1346–1349. [Google Scholar] [CrossRef] [PubMed]
- Hubbard, R.B.; Smith, C.; Le Jeune, I.; Gribbin, J.; Fogarty, A.W. The association between idiopathic pulmonary fibrosis and vascular disease: A population-based study. Am. J. Respir. Crit. Care Med. 2008, 178, 1257–1261. [Google Scholar] [CrossRef] [PubMed]
- Revuelta, F.; Arvelo-Castro, L.A.; Aguilar, M.; Martos, N.; Aguado, S.; Carrillo, J.; Ussetti, P. Coronary Disease and Lung Transplantation: Pulmonary Fibrosis is a cardiovascular risk factor? J. Heart Lung Transplant. 2017, 36, S402. [Google Scholar] [CrossRef]
- Whelan, T.P.; Dunitz, J.M.; Kelly, R.F.; Edwards, L.B.; Herrington, C.S.; Dahlberg, P.S. Effect of preoperative pulmonary artery pressure on early survival after lung transplantation for idiopathic pulmonary fibrosis. Pulmonary Medicine, Universitary Hospital Puerta de Hierro, Madrid, Spain. J. Heart Lung Transplant. 2005, 24, 1269–1274. [Google Scholar] [CrossRef] [PubMed]
- Raghu, G.; Freudenberger, T.D.; Yang, S.; Curtis, J.R.; Spada, C.J.; Hayes, C.E.; Pope, C.A. High prevalence of abnormal acidgastro-oesophageal reflux in idiopathic pulmonary fibrosis. Eur. Respir. J. 2006, 27, 136–142. [Google Scholar] [CrossRef] [PubMed]
- Savarino, E.; Carbone, R.; Marabotto, E.; Furnari, M. Gastro-oesophageal reflux and gastric aspiration in idiopathic pulmonary fibrosis patients. Eur. Respir. J. 2013, 42, 1322–1331. [Google Scholar] [CrossRef] [PubMed]
- Belkin, R.A.; Henig, N.R.; Singer, L.G.; Chaparro, C.; Rubenstein, R.C.; Xie, S.X.; Yee, J.Y.; Kotloff, R.M.; Lipson, D.A.; Bunin, G.R. Risk factors for death of patients with cystic fibrosis awaiting lung transplantation. Am. J. Respir. Crit. Care Med. 2006, 173, 659–666. [Google Scholar] [CrossRef] [PubMed]
- Vaquero, B.J.M.; Redel, M.J.; Santos, L.F. Comorbidities impacting on prognosis after lung transplant. Arch. Bronconeumol. 2014, 50, 25–33. [Google Scholar] [CrossRef]
- Justin, M.O.; Collard, H.R. Comorbid Conditions in Idiopathic Pulmonary Fibrosis: Recognition and Management. Front. Med. 2017, 4, 123. [Google Scholar]
- Dai, J.; Cai, H.; Li, H.; Zhuang, Y.; Min, H.; Wen, Y.; Yang, J.; Gao, Q.; Shi, Y.; Yi, L. Association between telomere length and survival in patients with idiopathic pulmonary fibrosis. Respirology 2015, 20, 947–952. [Google Scholar] [CrossRef] [PubMed]
- Cronkhite, J.T.; Xing, C.; Raghu, G.; Chin, K.M.; Torres, F.; Rosenblatt, R.L.; Garcia, C.K. Telomere shortening in familial and sporadic pulmonary fibrosis. Am. J. Respir. Crit. Care Med. 2008, 178, 729–737. [Google Scholar] [CrossRef] [PubMed]
- Newton, C.A.; Kozlitina, J.; Lines, J.R.; Kaza, V.; Torres, F.; Garcia, C.K. Telomere length in patients with pulmonary fibrosis associated with chronic lung allograft dysfunction and post-lung transplantation survival. J. Heart Lung Transplant. 2017, 36, 845–853. [Google Scholar] [CrossRef] [PubMed]
- Clausen, E.S.; Snyder, L.D. Do donors matter? Short telomeres and survival after lung transplant. Thorax 2017, 72, 965–966. [Google Scholar] [CrossRef] [PubMed]
- Silhan, L.L.; Shah, P.D.; Chambers, D.C.; Snyder, L.D.; Gerdt, C.R.; Wagner, C.L.; Hellström-Lindberg, E.; Orens, J.B.; Juliette, F.; Danoff, S.K.; et al. Lung transplantation in telomerase mutation carriers with pulmonary fibrosis. Eur. Respir. J. 2014, 44, 178–187. [Google Scholar] [CrossRef] [PubMed]
- Borie, R.; Kannengiesser, C.; Hirschi, S.; Le Pavec, J.; Mal, H.; Bergot, E.; Jouneau, S.; Naccache, J.M.; Revy, P.; Boutboul, D.; et al. Severe hematologic complications after lung transplantation in patients with telomerase complex mutations. J. Heart Lung Transplant. 2015, 34, 538–546. [Google Scholar] [CrossRef] [PubMed]
- King, T.E., Jr.; Schwarz, M.I.; Brown, K.; Tooze, J.A.; Colby, T.V.; Waldron, J.A., Jr.; Flint, A.; Thurlbeck, W.; Cherniack, R.M. Idiopathic pulmonary fibrosis: Relationship between histopathologic features and mortality. Am. J. Respir. Crit. Care Med. 2001, 164, 1025–1032. [Google Scholar] [CrossRef] [PubMed]
- Collard, H.R.; King, T.E., Jr.; Bartelson, B.B.; Vourlekis, J.S.; Schwarz, M.I.; Brown, K.K. Changes in clinical and physiologic variables predict survival in idiopathic pulmonary fibrosis. Am. J. Respir. Crit. Care Med. 2003, 168, 538–542. [Google Scholar] [CrossRef] [PubMed]
- Raghu, G.; Collard, H.R.; Egan, J.J.; Martinez, F.J.; Behr, J.; Brown, K.K.; Colby, T.V.; Cordier, J.F.; Flaherty, K.R.; Lasky, J.A.; et al. An official ATS/ERS/JRS/ALAT statement: Idiopathic pulmonary fibrosis: Evidence-based guidelines for diagnosis and management. Am. J. Respir. Crit. Care Med. 2011, 183, 788–824. [Google Scholar] [CrossRef] [PubMed]
- Fisher, J.H.; Al-Hejaili, F.; Kandel, S.; Hirji, A.; Shapera, S.; Mura, M. Multi-dimensional scores to predict mortality in patients with idiopathic pulmonary fibrosis undergoing lung transplantation assessment. Respir. Med. 2017, 125, 65–71. [Google Scholar] [CrossRef] [PubMed]
- Salisbury, M.L.; Xia, M.; Zhou, Y.; Murray, S.; Tayob, N.; Brown, K.K.; Wells, A.U.; Schmidt, S.L.; Martinez, F.J.; Flaherty, K.R. Idiopathic Pulmonary Fibrosis: Gender-Age-Physiology Index Stage for Predicting Future Lung Function Decline. Chest 2016, 149, 491–498. [Google Scholar] [CrossRef] [PubMed]
- Raghu, G.; Rochwerg, B.; Zhang, Y.; Garcia, C.A.; Azuma, A.; Behr, J.; Brozek, J.L.; Collard, H.R.; Cunningham, W.; Homma, S.; et al. An Official ATS/ERS/JRS/ALAT Clinical Practice Guideline: Treatment of Idiopathic Pulmonary Fibrosis. An Update of the 2011 Clinical Practice Guideline. Am. J. Respir. Crit. Care Med. 2015, 192, e3–e19. [Google Scholar] [CrossRef] [PubMed]
- Mortensen, A.; Cherrier, L.; Walia, R. Effect of pirfenidone on wound healing in lung transplant patients. Multidiscip. Respir. Med. 2018, 13, 16. [Google Scholar] [CrossRef] [PubMed]
- European Medicines Agency. Ofev: European Public Assessment Report-Product Information; European Medicines Agency: London, UK, 2017. [Google Scholar]
- Delanote, I.; Wuyts, W.A.; Yserbyt, J.; Verbeken, E.K.; Verleden, G.M.; Vos, R. Safety and efficacy of bridging to lung transplantation with antifibrotic drugs in idiopathic pulmonary fibrosis: A case series. BMC Pulm. Med. 2016, 16, 156. [Google Scholar] [CrossRef] [PubMed]
- Leuschner, G.; Stocker, F.; Veit, T.; Kneidinger, N.; Winter, H.; Schramm, R.; Weig, T.; Matthes, S.; Ceelen, F.; Arnold, P.; et al. Outcome of lung transplantation in idiopathic pulmonary fibrosis with previous anti-fibrotic therapy. J. Heart Lung Transplant. 2018, 37, 268–274. [Google Scholar] [CrossRef] [PubMed]
- Lambers, C.; Boehm, P.M.; Lee, S.; Ius, F.; Jaksch, P.; Klepetko, W.; Tudorache, I.; Ristl, R.; Welte, T.; Gottlieb, J. Effect of antifibrotics on short-term outcome after bilateral lung transplantation: A multicentre analysis. Eur. Respir. J. 2018, 51, 1800503. [Google Scholar] [CrossRef] [PubMed]
- Balestro, E.; Solidoro, P.; Parigi, P.; Boffini, M.; Lucianetti, A.; Rea, F. Safety of nintedanib before lung transplant: An Italian case series. Respirol. Case Rep. 2018, 6, e00312. [Google Scholar] [CrossRef] [PubMed]
- McAnally, K.J.; Valentine, V.G.; La Place, S.G.; McFadden, P.M.; Seoane, L.; Taylor, D.E. Effect of pre-transplantation prednisone on survival after lung transplantation. J. Heart Lung Transplant. 2006, 25, 67–74. [Google Scholar] [CrossRef] [PubMed]
- Schafers, H.J.; Wagner, T.O.; Demertzis, S.; Hamm, M.; Wahlers, T.; Cremer, J.; Haverich, A. Preoperative corticosteroids. A contraindication to lung transplantation? Chest 1992, 102, 1522–1525. [Google Scholar] [CrossRef]
- Park, S.J.; Nguyen, D.Q.; Savik, K.; Hertz, M.I.; Bolman, R.M., 3rd. Pre-transplant corticosteroid use and outcome in lung transplantation. J. Heart Lung Transplant. 2001, 20, 304–309. [Google Scholar] [CrossRef]
- Puri, V.; Patterson, G.A.; Meyers, B.F. Single versus bilateral lung transplantation: Do guidelines exist? Thorac. Surg. Clin. 2015, 25, 47–54. [Google Scholar] [CrossRef] [PubMed]
- Aryal, S.; Nathan, S.D. Single vs. Bilateral lung transplantation: When and why. Curr. Opin. Organ Transp. 2018, 23, 316–323. [Google Scholar] [CrossRef] [PubMed]
- Nathan, S.D.; Shlobin, O.A.; Ahmad, S.; Burton, N.A.; Barnett, S.D.; Edwards, E. Comparison of wait times and mortality for idiopathic pulmonary fibrosis patients listed for single or bilateral lung transplantation. J. Heart Lung Transplant. 2010, 29, 1165–1171. [Google Scholar] [CrossRef] [PubMed]
- Ten Klooster, L.; Nossent, G.D.; van Erp, J.M.; van Kessel, D.A.; Oudijk, E.J.; van de Graaf, E.A.; Luijk, B.; Hoek, R.A.; van den Blink, B.; van Hal, P.T.; et al. Ten-Year Survival in Patients with Idiopathic Pulmonary Fibrosis After Lung Transplantation. Lung 2015, 193, 919–926. [Google Scholar] [CrossRef] [PubMed]
- Schaffer, J.M.; Singh, S.K.; Reitz, B.A.; Zamanian, R.T.; Mallidi, H.R. Single- vs. double-lung transplantation in patients with chronic obstructive pulmonary disease and idiopathic pulmonary fibrosis since the implementation of lung allocation based on medical need. JAMA 2015, 313, 936–948. [Google Scholar] [CrossRef] [PubMed]
- Gulack, B.C.; Ganapathi, A.M.; Speicher, P.J.; Meza, J.M.; Hirji, S.A.; Snyder, L.D.; Davis, R.D.; Hartwig, M.G. What Is the Optimal Transplant for Older Patients with Idiopathic Pulmonary Fibrosis? Ann. Thorac. Surg. 2015, 100, 1826–1833. [Google Scholar] [CrossRef] [PubMed]
- Mogulkoc, N.; Brutsche, M.H.; Bishop, P.W.; Greaves, S.M.; Horrocks, A.W.; Egan, J.J. Greater Manchester Pulmonary Fibrosis Consortium. Pulmonary function in idiopathic pulmonary fibrosis and referral for lung transplantation. Am. J. Respir. Crit. Care Med. 2001, 164, 103–108. [Google Scholar] [CrossRef] [PubMed]
- Bartels, M.N.; Armstrong, H.F.; Gerardo, R.E.; Layton, A.M.; Emmert-Aronson, B.O.; Sonnet, J.R.; Arcasoy, S.M. Evaluation of pulmonary function and exercise performance by cardiopulmonary exercise testing before and after lung transplantation. Chest 2011, 140, 1604–1611. [Google Scholar] [CrossRef] [PubMed]
- Rubin, A.S.; Nascimento, D.Z.; Sanchez, L.; Watte, G.; Holand, A.R.; Fassbind, D.A.; Camargo, J.J. Functional improvement in patients with idiopathic pulmonary fibrosis undergoing single lung transplantation. J. Bras. Pneumol. 2015, 41, 299–304. [Google Scholar] [CrossRef] [PubMed]
- Elisabeth, C.; Santos, F.; Ussetti, P.; Canela, M.; Borro, J.M.; De La Torre, M.; Varela, A.; Zurbano, F.; Mons, R.; Morales, P.; et al. Registro Español de Trasplante Pulmonar: Primer informe de resultados (2006–2010). Arch. Bronconeumol. 2013, 49, 70–78. [Google Scholar]
- Thabut, G.; Mal, H.; Castier, Y.; Groussard, O.; Brugière, O.; Marrash-Chahla, R.; Lesèche, G.; Fournier, M. Survival benefit of lung transplantation for patients with idiopathic pulmonary fibrosis. J. Thorac. Cardiovasc. Surg. 2003, 126, 469–475. [Google Scholar] [CrossRef]
- Gottlieb, J. Lung transplantation for interstitial lung diseases. Curr. Opin. Pulm. Med. 2014, 20, 457–462. [Google Scholar] [CrossRef] [PubMed]
- Berastegui, C.; Monforte, V.; Bravo, C.; Sole, J.; Gavalda, J.; Tenório, L.; Villar, A.; Rochera, M.I.; Canela, M.; Morell, F.; et al. Trasplante pulmonar en la fibrosis pulmonar idiopática y otras enfermedades pulmonares intersticiales. Med. Clin. 2014, 143, 239–244. [Google Scholar] [CrossRef] [PubMed]
- Kumar, A.; Kapnadak, S.G.; Girgis, R.E.; Raghu, G. Lung transplantation in idiopathic pulmonary fibrosis. Exp. Rev. Respir. Med. 2018, 12, 375–385. [Google Scholar] [CrossRef] [PubMed]
- Kugler, C.; Gottlieb, J.; Warnecke, G.; Schwarz, A.; Weissenborn, K.; Barg-Hock, H.; Bara, C.; Einhorn, I.; Haverich, A.; Haller, H. Health-Related Quality of Life After Solid Organ Transplantation: A Prospective, Multiorgan Cohort Study. Transplantation 2013, 96, 316–323. [Google Scholar] [CrossRef] [PubMed]
- Singer, J.P.; Katz, P.P.; Soong, A.; Shrestha, P.; Huang, D.; Ho, J.; Mindo, M.; Greenland, J.R.; Hays, S.R.; Golden, J.; et al. Effect of Lung Transplantation on Health-Related Quality of Life in the Era of the Lung Allocation Score: A U.S. Prospective Cohort Study. Am. J. Transplant. 2017, 17, 1334–1345. [Google Scholar] [CrossRef] [PubMed]
- Van Muylem, A.; Melot, C.; Antoine, M.; Knoop, C.; Estenne, M. Role of pulmonary function in the detection of allograft dysfunction after heart–lung transplantation. Thorax 1997, 52, 643–647. [Google Scholar] [CrossRef] [PubMed]
- Kluger, C.; Fuehner, T.; Dierich, M.; DeWall, C.; Haverich, A.; Simon, A.; Welte, T.; Gottlieb, J. Effect of adherence to home spirometry on bronchiolitis obliterans and graft survival after lung transplantation. Trasplantation 2009, 88, 129–134. [Google Scholar]
- Gregson, A.L.; Hoji, A.; Saggar, R.; Ross, D.J.; Kubak, B.M.; Jamieson, B.D.; Weight, S.S.; Lynch, J.P., 3rd; Ardehali, A.; Belperio, J.A.; et al. Bronchoalveolar immunologic profile of acute human lung transplant allograft rejection. Transplantation 2008, 85, 1056–1059. [Google Scholar] [CrossRef] [PubMed]
- Fruchter, O.; Fridel, L.; Rosengarten, D.; Raviv, Y.; Rosanov, V.; Kramer, M.R. Transbronchialcryo-biopsy in lung transplantation patients: First Report. Respirology 2013, 18, 669–673. [Google Scholar] [CrossRef] [PubMed]
- Brown, A.W.; Kaya, H.; Nathan, S.D. Lung transplantation in IIP: A review. Respirology 2016, 21, 1173–1184. [Google Scholar] [CrossRef] [PubMed]
- Kotton, D.K.; Caliendo, A.M.; Huprikar, S.; Chou, S.; Danziger-Isakov, L.; Humar, A. The Transplantation Society International CMV Consensus Group. The third international consensus guidelines on the management of cytomegalovirus in solid organ transplantation. Transplantation 2018, 102, 900–931. [Google Scholar] [CrossRef] [PubMed]
- Kennedy, C.C.; Razonable, R.R. Fungal Infections After Lung Transplantation. Clin. Chest Med. 2017, 38, 511–520. [Google Scholar] [CrossRef] [PubMed]
- Weigt, S.S.; Wallace, W.D.; Derhovanessian, A.; Saggar, R.; Saggar, R.; Lynch, J.P.; Belperio, J.A. Chronic allograft rejection: Epidemiology, diagnosis, pathogenesis, and treatment. Semin. Respir. Crit. Care Med. 2010, 31, 189–207. [Google Scholar] [CrossRef] [PubMed]
- Sato, M.; Waddell, T.K.; Wagnetz, U.; Roberts, H.C.; Hwang, D.M.; Haroon, A.; Wagnetz, D.; Chaparro, C.; Singer, L.G.; Hutcheon, M.A.; et al. Restrictive allograft syndrome (RAS): A novel form of chronic lung allograft dysfunction. J. Heart Lung Transplant. 2011, 30, 735–742. [Google Scholar] [CrossRef] [PubMed]
- Verleden, G.M.; Vos, R.; Verleden, S.E.; De Wever, W.; De Vleeschauwer, S.I.; Willems-Widyastuti, A.; Scheers, H.; Dupont, L.J.; Van Raemdonck, D.E.; Vanaudenaerde, B.M. Survival Determinants in Lung Transplant Patients with Chronic Allograft Dysfunction. Transplantation 2011, 92, 703–708. [Google Scholar] [CrossRef] [PubMed]
- Kennedy, V.E.; Todd, J.L.; Palmer, S.M. Bronchoalveolar Lavage as a Tool to Predict, Diagnose and Understand Bronchiolitis Obliterans Syndrome. Am. J. Transp. 2013, 13, 552–561. [Google Scholar] [CrossRef] [PubMed]
- Verleden, S.E.; Vos, R.; Mertens, V.; Willems-Widyastuti, A.; De Vleeschauwer, S.I.; Dupont, L.J.; Verleden, G.M.; Van Raemdonck, D.E.; Vanaudenaerde, B.M. Heterogeneity of chronic lung allograft dysfunction: Insights from protein expression in bronchoalveolar lavage. J. Heart Lung Transplant. 2011, 30, 667–673. [Google Scholar] [CrossRef] [PubMed]
- Laporta, R. Utilidad Clínica del Análisis de las Células y las Citoquinas en el Lavado Broncoalveolar de Pacientes con Disfunción Crónica del Injerto Pulmonar. Ph.D. Thesis, Universidad Autónoma de Madrid, Madrid, Spain, September 2017. [Google Scholar]
- Hachem, R.; Corris, P. Extracorporeal Photopheresis for Bronchiolitis Obliterans Syndrome After Lung Transplantation. Transplantation 2018, 102, 1059–1065. [Google Scholar] [CrossRef] [PubMed]
- Ihle, F.; von Wulffen, W.; Neurohr, C. Pirfenidone: A potential therapy for progressive lung allograft dysfunction? J. Heart Lung Transplant. 2013, 32, 574–575. [Google Scholar] [CrossRef] [PubMed]
- Suhling, H.; Bollmann, B.; Gottlieb, J. Nintedanib in restrictive chronic lung allograft dysfunction after lung transplantation. J. Heart Lung Transplant. 2016, 35, 939–940. [Google Scholar] [CrossRef] [PubMed]
- Berastegui, C.; Laporta, R.; López-Meseguer, M.; Romero, L.; Gómez-Ollés, S.; Riera, J.; Monforte, V.; Sáez, B.; Bravo, C.; Roman, A.; et al. Epidemiology and Risk Factors for Cancer After Lung Transplantation. Transp. Proc. 2017, 49, 2285–2291. [Google Scholar] [CrossRef] [PubMed]
- Van Raemdonck, D.; Vos, R.; Yserbyt, J.; Decaluwe, H.; De Leyn, P.; Verleden, G.M. Lung cancer: A rare indication for, but frequent complication after lung transplantation. J. Thorac. Dis. 2016, 8, S915–S924. [Google Scholar] [CrossRef] [PubMed]
- Pérez-Callejo, D.; Torrente, M.; Parejo, C.; Laporta, R.; Ussetti, P.; Provencio, M. Lung cancer in lung transplantation: Incidence and outcome. J. Postgrad. Med. 2018, 94, 15–19. [Google Scholar] [CrossRef] [PubMed]

| Indications |
| High risk of death (>50%) in the following two years without transplant |
| High probability (>80%) of surviving at least 90 days after transplantation |
| High probability (>80%) of surviving 5 years after transplantation of any general medical condition |
| Absolute Contraindications |
| Recent tumor history (>5 years free of disease) |
| Dysfunction of another major organ |
| Nonvascularizable coronary disease |
| Hemorrhagic diathesis |
| Deformities of the chest wall |
| Morbid obesity |
| Tuberculosis infection |
| Infection by highly resistant germs without control |
| Severely altered functional status with inability to rehabilitate |
| Severe psychiatric disorders |
| Poor social support |
| Nonadherence to treatment |
| Relative Contraindications |
| Age > 65 years |
| Obesity (BMI 30–34.9) |
| Severe malnutrition |
| Symptomatic severe osteoporosis |
| Previous thoracic surgery with pulmonary resection |
| Mechanical ventilation and/or extracorporeal support |
| Infection by virus B or C with evidence of significant liver injury and/or portal hypertension |
| Criteria for Referral to Transplant Units |
| Histopathologic diagnosis of UIP or fibrotic NSIP |
| FVC < 80% and/or DLCO < 40% |
| Dyspnea or functional limitation attributable to lung disease |
| Requirement of oxygen therapy in exercise or at rest |
| Lack of response to treatment |
| Criteria for Inclusion in the Waiting List |
| Decrease ≥ 10% of FVC during 6 months of follow-up |
| Decrease ≥ 15% of the DLCO during 6 months of follow-up |
| Desaturation < 88% or distance < 250 m during 6MWT or descent > 50 m in the distance walked, during 6 months of follow-up |
| Pulmonary hypertension |
| Hospitalization due to deterioration, pneumothorax, or acute exacerbation |
| GAP Score | Stage | One Year Mortality | Recommendation |
|---|---|---|---|
| 0–3 | I | 5.6% | Follow-up |
| 4–5 | II | 16.2% | Individualize according to evolution and waiting time |
| 6–8 | III | 39.2% | Include in the waiting list |
| Immunosuppressive Drugs | Side Effects |
|---|---|
| Corticosteroids | Hypertension, hyperlipidemia, hypocalcemia, osteoporosis, weight gain, cataracts, and psychological symptoms |
| Antimetabolites (mycophenolate, azathioprine) | Myelosuppression, hepatotoxicity, alopecia, gastrointestinal intolerance, acute pancreatitis, infections, and neoplasia |
| Calcineurininhibitors (cyclosporine, tacrolimus) | Nephrotoxicity, hypertension, hyperuricemia, hyperkalemia, diabetes, hyperlipidemia, neurotoxicity, gingival hyperplasia, infections, and lymphoproliferative disease |
| Inhibitors of mammalian Target of Rapamycin (everolimus, rapamycin) | Hyperlipidemia, diabetes, edema, proteinuria, and pneumonitis |
© 2018 by the authors. Licensee MDPI, Basel, Switzerland. This article is an open access article distributed under the terms and conditions of the Creative Commons Attribution (CC BY) license (http://creativecommons.org/licenses/by/4.0/).
Share and Cite
Laporta Hernandez, R.; Aguilar Perez, M.; Lázaro Carrasco, M.T.; Ussetti Gil, P. Lung Transplantation in Idiopathic Pulmonary Fibrosis. Med. Sci. 2018, 6, 68. https://doi.org/10.3390/medsci6030068
Laporta Hernandez R, Aguilar Perez M, Lázaro Carrasco MT, Ussetti Gil P. Lung Transplantation in Idiopathic Pulmonary Fibrosis. Medical Sciences. 2018; 6(3):68. https://doi.org/10.3390/medsci6030068
Chicago/Turabian StyleLaporta Hernandez, Rosalía, Myriam Aguilar Perez, María Teresa Lázaro Carrasco, and Piedad Ussetti Gil. 2018. "Lung Transplantation in Idiopathic Pulmonary Fibrosis" Medical Sciences 6, no. 3: 68. https://doi.org/10.3390/medsci6030068
APA StyleLaporta Hernandez, R., Aguilar Perez, M., Lázaro Carrasco, M. T., & Ussetti Gil, P. (2018). Lung Transplantation in Idiopathic Pulmonary Fibrosis. Medical Sciences, 6(3), 68. https://doi.org/10.3390/medsci6030068

